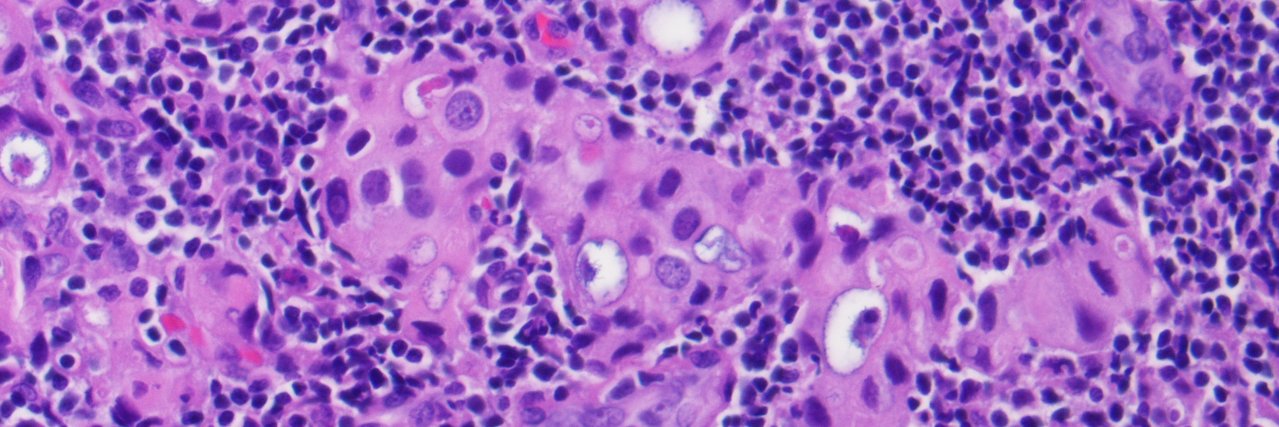
keithkaplanmd banner

keithkaplanmd
10.5K posts

keithkaplanmd
@keithkaplanmd
Surgical pathologist passionate about using technology for new discoveries and practice of medicine.
Chicago, IL Katılım Temmuz 2008
852 Takip Edilen6.9K Takipçiler

Check out my latest article: Is Digital Pathology Better, Faster, Cheaper, More Accurate? No, but it is essential for survival. linkedin.com/pulse/digital-… via @LinkedIn
English
keithkaplanmd retweetledi

This is Rabbi Scheier. He heads the largest Conservative Jewish congregation in Montreal.
He was asked to leave an area of downtown Montreal because... he's visibly Jewish.
This is the Canada that Trudeau will be leaving behind in October. This is his legacy.
#Antisemitism


English
keithkaplanmd retweetledi

For anyone interested in learning more about angiography, come check out my introductory guide!
Come see my annotated diagrams like the one shown below.
intuitivecardiology.notion.site/angiography

English
keithkaplanmd retweetledi

Special thank you to our 6 new followers from Nigeria, and more last week. fedica.com/!tissuepatholo…

English
keithkaplanmd retweetledi

Hint:
1) Americans don’t like mud slinging-especially when politicians, the media and celebrities sling it at the voters
2) Americans don’t like socialism or communism
3) Americans don’t like to be told what to do, how to do it and when to do it
4) Americans don’t like foreign countries/citizens being taken care of before our own country/citizens
English

Special thank you to our 5 new followers from USA, and more last week. fedica.com/!tissuepatholo…

English

Check out my latest article: What is Going on in Pathology? linkedin.com/pulse/what-goi… via @LinkedIn
English


@PaigeSpiranac Nobody, I mean nobody puts ketchup on a hot dog. Dirty Harry (Sudden Impact). He’s right.
Elk Grove Village, IL 🇺🇸 English

Only need one thing. Ketchup.
What’s For Dinner? 🍽️@WHATSFORDlNNER
You can only add two things.
English
keithkaplanmd retweetledi

April 29, 1983: (*NSFW*) Chicago Cubs manager Lee Elia’s incredible rant.
#LeeEliaDay #DayGames
English
keithkaplanmd retweetledi

Special thank you to our 8 new followers from Iran, and more last week. fedica.com/!tissuepatholo…

English

Special thank you to our 8 new followers from South Africa, and more last week. fedica.com/!tissuepatholo…

English

Check out my latest article: Digital pathology is just pathology, but does it matter anymore? linkedin.com/pulse/digital-… via @LinkedIn
English
keithkaplanmd retweetledi

I have never seen an economist explain how it could be possible for the United States to survive its growing debt burden.
Does anyone have a serious explanation how this is survivable?
Seems too big to inflate away, and I see no way GDP increases enough to make it up.
Do we issue a new crypto currency of some sort and invent money from nothing?
Does the coming robot/AI era goose our GDP so much we pay off the debt in time?
Do we start charging our smaller allies for "protection"?
Name any scenario in which America survives its debt burden.
English

keithkaplanmd retweetledi

IDF Ground Operations in Gaza continued and expanded overnight:
🔻An IAF aircraft—guided by ground forces—struck a Hamas post and the 20+ terrorist operatives in it.
🔻Soldiers spotted armed terrorists and an anti-tank missile launching post near the Al-Azhar University and guided an IAF fighter jet to strike them.
🔻IDF forces eliminated multiple terrorists barricaded within civilian buildings and terrorist tunnels who attempted to attack the forces.
English






